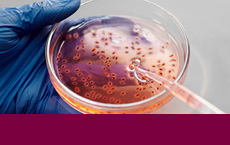

Übersicht

Automotive und Elektromobilität

Chemie

Elektro-, Informations- und Kommunikationstechnik

Energietechnik und Ern. Energien

Gesundheit

Informationsservice und Dienstleistungen
Lebenswissenschaften

Maschinenbau

Material- und Werkstofftechnik

Medizintechnik

Mobilität (Sonstiges)

Neurowissenschaften

Pharma

Software und Digital Engineering

Verfahrenstechnik

IQ Innovationspreis



